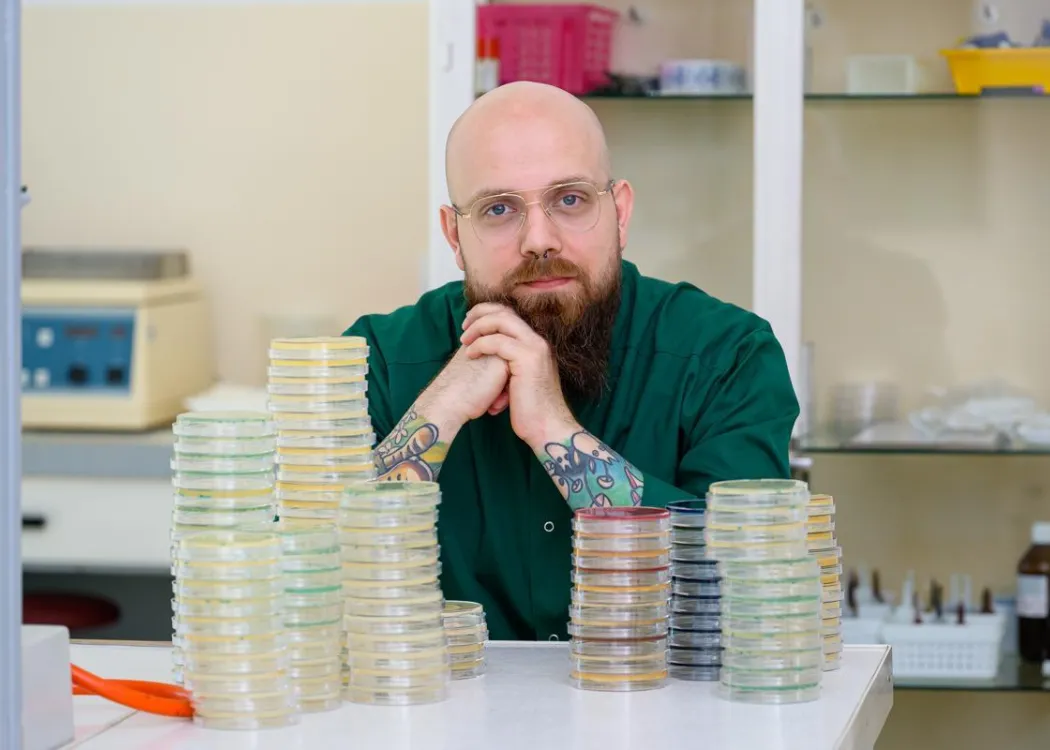
Dr inż. Arkadiusz Zakrzewski

15 Października 2025
Aktualności
Dr inż. Arkadiusz Zakrzewski jest adiunktem w Katedrze Mikrobiologii Żywności, Technologii i Chemii Mięsa. Na swoim koncie ma prestiżowe nagrody. Był stypendystą ministra oraz znalazł się w gronie 100 wybitnych młodych naukowców wyróżnionych w programie START Fundacji na rzecz Nauki Polskiej. Był też pierwszym studentem w historii UWM, który zdobył Diamentowy Grant. Projekt „Warunki stresowe podczas otrzymywania produktów sous-vide i ceviche z ryb i krewetek a możliwość przeżycia oraz odpowiedź komórkowa bakterii wieloopornych” realizował wówczas w zespole dr hab. inż. Anny Zadernowskiej i dr hab. inż. Wiolety Chajęckiej-Wierzchowskiej, które były też promotorkami jego rozprawy doktorskiej.
– Określałem wówczas częstotliwość występowania antybiotykoopornych szczepów z rodziny Enterobacteriaceae, rodzaju Listeria oraz Enterococcus w surowych rybach i krewetkach dostępnych na rynku polskim. Ponadto badałem wpływ stresu środowiskowego podczas obróbki sous-vide i ceviche na komórki bakterii opornych na antybiotyki – wyjaśniał badacz.
Nagroda Prezesa Rady Ministrów za kompleksowe podejście
Wnikliwe badania zaowocowały rozprawą doktorską pt. „Warunki stresowe podczas otrzymywania produktów gotowych do spożycia z ryb i krewetek a możliwość przeżycia oraz odpowiedź komórkowa bakterii z rodzaju Listeria sp.”, której wartość merytoryczną doceniono właśnie Nagrodą Prezesa Rady Ministrów. Przypomnijmy, że wyróżniające się prace zgłaszane są nie przez samych kandydatów do nagrody, ale przez wyższe uczelnie i instytuty naukowe. Zgodnie z rozporządzeniem wnioskodawcą jest rektor lub dyrektor instytutu naukowego, a uzasadnienie wniosku to uchwała senatu uczelni lub rady naukowej instytutu. Rekomendacji nie może udzielić osoba w jakikolwiek sposób związana z powstaniem ocenianego osiągnięcia (promotor, recenzent, współautor) oraz zatrudniona w tym samym podmiocie. Rozprawę dr. Arkadiusza Zakrzewskiego rekomendowała prof. dr hab. Małgorzata Gniewosz, która doceniła kompleksowość wyjaśnień, które w swoim doktoracie zawarł młody naukowiec.
Dodajmy, że na czele zespołu ds. nagród stoi aktualnie prof. dr hab. Piotr Suwalski, dyrektor Państwowego Instytutu Medycznego MSWiA. Reprezentantem UWM w tym gremium jest z kolei prof. dr hab. Andrzej Krankowski (inżynieria lądowa, geodezja i transport).
Kariera napędzana pasją
Kilka miesięcy temu dr inż. Arkadiusz Zakrzewski otrzymał grant z programu Lider Narodowego Centrum Badań i Rozwoju. Kwota ponad 1,7 mln złotych ma mu umożliwić prowadzenie badań, których cel zawarł w tytule grantu: „Opracowanie bioochronnego preparatu z inaktywowanych szczepów o niskim indeksie MAR i obniżonym potencjale transferu genów w ramach strategii One Health – poprawa trwałości żywności i kontrola zanieczyszczeń Listeria monocytogenes”.
O swoim sukcesie mówił na łamach „Wiadomości Uniwersyteckich”: – Wszystkie badania, które prowadziłem do tej pory, były tak naprawdę badaniami podstawowymi, czyli prace eksperymentalne czy teoretyczne podejmowałem przede wszystkim w celu zdobycia nowej wiedzy bez nastawienia na bezpośrednie zastosowanie komercyjne. Program Lider wspiera młodych naukowców w samodzielnym prowadzeniu projektów badawczych i zarządzaniu własnym zespołem. Stawia na innowacje, które mogą znaleźć zastosowanie poza laboratorium – w przemyśle i codziennym życiu. Będąc na stażu w Finlandii, miałem przyjemność poznać prof. Seppo Salminena, który jest specjalistą od probiotyków, prebiotyków i postbiotyków. O ile te dwa pierwsze były mi znane, to z postbiotykami spotkałem się pierwszy raz i bardzo mnie zainteresowały. Postanowiłem wykorzystać zdobytą wiedzę i poprowadzić własne badania. Nie odbiegam w nich jednak mocno od swoich zainteresowań, które skupiają się nad Listeria monocytogenes, rybach i antybiotykooporności.
Kariera dr. inż. Arkadiusza Zakrzewskiego rozwija się w zawrotnym tempie właściwie już od czasu studiów.
– Na studiach doktoranckich aplikowałem o grant z Preludium i jako jeden z niewielu mogłem pochwalić się tym, że byłem już kierownikiem projektu. Dużo pracuję, jestem znany portierom, że jako ostatni wychodzę z budynku. Mam wiele pomysłów – zaznaczył. – Nie wykluczam, że jeszcze w tym roku będę aplikował o kolejny grant. Nawet jeśli nie uda mi się go uzyskać, to dzięki recenzjom będę mógł go ulepszyć. Jestem dumny z tego, że od pierwszego dnia na studiach doktoranckich aż do dzisiaj mam ciągłość w realizacji projektów i chciałbym ją utrzymać.
dbp
>>> Rozmowa z dr. inż. Arkadiuszem Zakrzewskim na temat bezpieczeństwa żywności ukazała się w wakacyjnym wydaniu „Wiadomości Uniwersyteckich”.